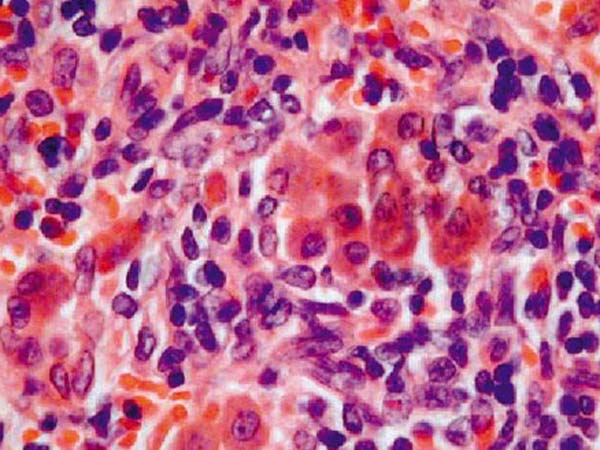
ஸ்டெம் செல் கல்லீரல்

கல்லீரல் நோய்களுக்கு கவலையில்லை… மனித ஸ்டெம்செல்லில் கல்லீரல் உருவாக்கி சாதனை!
உடலின் வளர்சிதை மாற்றம், புரோட்டீன் உற்பத்தி, ரத்த உறைவு உட்பட பல முக்கிய செயல்களை கல்லீரல்தான் செய்கிறது.
நம் உடலின் மையத்தில் உள்ள கல்லீரல், முற்றிலும் பாதிக்கப்பட்டுவிட்டால் மற்ற உறுப்புகளும் படிப்படியாக செயலிழக்க ஆரம்பித்து விடும். எனவே கல்லீரலை கவனமாக காக்க வேண்டும். அது நம் கையில் தான் உள்ளது.
பசி இல்லாமை, உடல் சோர்வு, எடை குறைதல், மயக்கம், கால் வீக்கம், ரத்த வாந்தி, ரத்தம் வெளியேறுதல் போன்றவை கல்லீரல் பாதிப்பின் அறிகுறிகள். ஆனால் கல்லீரல் 70 சதவீதம் பாதிக்கும் வரை நிறைய பேருக்கு அறிகுறிகள் தெரிவது இல்லை.

நோய்க்கு காரணங்கள்
மது அருந்துதல், கொழுப்பு மிக்க துரித உணவு, சுகாதாரமற்ற உணவு சாப்பிடுவது, தூய்மையற்ற தண்ணீர் அருந்துவது, அதிக உடல் எடை, உடல் பருமன், டென்ஷன் அடைவது, சர்க்கரை நோய், ரத்தம் பெறும் போது ஏற்படும் தொற்று போன்ற பல்வேறு காரணங்களால் கல்லீரல் நோய்கள் உண்டாகின்றன.

கல்லீரல் புற்றுநோய்
சில குழந்தைகளுக்கு பிறக்கும் போதே என்சைம் கோளாறுகளால் கல்லீரல் பாதிப்பு ஏற்படுகிறது. அத்துடன் மஞ்சள் காமாலை மற்றும் பலவகை ஹெபடைடிஸ், கல்லீரல் வீக்கம், கல்லீரல் சுருக்கம், கல்லீரல் புற்றுநோய், கல்லீரலில் கட்டிகள் போன்றவை முக்கிய நோய்கள்.

கல்லீரல் அறுவை சிகிச்சை
மஞ்சள் காமாலை போன்றவை உடனடி சிகிச்சையின் மூலம் குணமாகும். மற்ற கல்லீரல் நோய்களுக்கும் தொடர் சிகிச்சைகள் தடுப்பூசிகள் உள்ளன. ஆனால் முற்றிலும் பாதிக்கப்பட்டு விட்டால் கல்லீரல் மாற்று அறுவை சிகிச்சை தான் ஒரே வழி என்ற நிலைதான் உள்ளது.
ஸ்டெம் செல் கல்லீரல்
இதற்கான முக்கியத்துவத்தை உணர்ந்து ஜப்பானில் உள்ள யோகோ ஹமா பல்கலைக்கழகத்தை சேர்ந்த தகனோரி தகாபோ, ஹிடெகி தன்குசி என்ற 2 விஞ்ஞானிகள் மனித ஸ்டெம்செல் மூலம் கல்லீரல் உருவாக்கி சாதனை படைத்துள்ளனர். ஏற்கனவே இருக்கும் கல்லீரலில் ‘புளுரிபொடென்ட்' ஸ்டெம்செல்களை செலுத்தி புதிய கல்லீரலை வளர செய்தனர்.

கால்லீரல் தானம் எளிதாகும்
ஸ்டெம் செல் மூலம் மனிதர்களின் உடல் உறுப்புகளை விஞ்ஞானிகள் உருவாக்கி வருவது போல்
மிக முக்கிய உறுப்பான கல்லீரலையும் ஸ்டெம்செல் மூலம் உருவாக்கி சாதனை படைத்துள்ளனர். இதன் மூலம் கல்லீரல் தானம் பெறுவோர் பயனடைவர் என டாக்டர்கள் தெரிவித்துள்ளனர்.
-
இந்தா ஆரம்பிச்சுட்டாங்கல்ல.. திருச்சி இடை தேர்தலில் திமுகவில் சீட் யாருக்கு! ரேசில் அன்பில் - இனிகோ! -
தவெகவின் முதல் ராஜ்யசபா எம்.பி யார்? 4 பேரில் ஒருவர் பெயரை 'டிக்' அடிக்க ரெடியாகும் விஜய்! -
20 நிமிடம்.. அஜித்குமார் தாயாருக்கு முதல்வர் விஜய் நேரில் அஞ்சலி.. சென்னை வீட்டுக்கு சென்று ஆறுதல் -
"விஜய்" பெயரை யாரும் சொல்லக் கூடாது.. வார்த்தையைவிட்ட துணை சபாநாயகர்.. பத்திரிகையாளர் சொன்ன பதில்! -
திமுகவை தோற்கடித்த 8 அதிர்ச்சி காரணங்கள்.. ஸ்டாலின் மேஜைக்கு போன இறுதி ரிப்போர்ட்.. உள்ளே ஷாக்! -
ஓரம் கட்டப்பட்ட சித்தராமையா.. ஆட்சி அமைக்க டி.கே.சிவகுமாருக்கு ஆளுநர் அழைப்பு! ஆட்டம் ஆரம்பம் -
விஜய் என் வீடு தேடி வந்து எனக்கு துணை முதல்வர் பதவி கொடுத்திருப்பார்! பிரேமலதா பரபரப்பு தகவல் -
என்னை தொட்டிருக்கவே கூடாது.. கோவையில் வேலுமணிக்கு தண்ணி காட்டும் எடப்பாடி.. அடித்து ஆடும் வேலுசாமி -
விஜய்-ஐ அடித்து மேலே வந்த சிவக்குமார்.. லீமா ரோஸ் கொடுத்த ஷாக்! -
கொஞ்சம் அவகாசம் கொடுங்க.. எங்களுக்கு ஓட்டு போட்டதற்கு பெருமையடைய வைப்போம்.. அமைச்சர் ரமேஷ் -
ஒரு 'நாளுக்கு' ரூ.22.63 லட்சம் சம்பளம் வாங்கும் இன்போசிஸ் ஊழியர்.. யாருப்பா அது! -
திருமணம் முதல் அஜித் தாயார் அஞ்சலி வரை! சுப, துக்க நிகழ்வுகளில் மட்டும் விஜய்யுடன் வருகிறாரா த்ரிஷா?












Click it and Unblock the Notifications